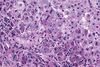

Liver Pathology Flashcards
(37 cards)
Diffuse bridging fibrosis and nodular regeneration via stellate cells disrupts normal architecture of liver
Cirrhosis
Cirrhosis top 2 etiology?
Alcohol and Viral
Acute pancreatitis markers?
amylase and Lipase
More specific for Acute pancreatitis?
Lipase (amylase is everywhere)
Alkaline phosphatase (ALP) in cirrhoris?
Cholestasis, HCC, Bone
Alcoholic AST vs ALT
Alcoholic hepatitis (AST > ALT)
Ceruloplasmin is decreased in?
Wilson disease
γ-glutamyl transpeptidase (GGT) is elevated similar to ALP except one thing is not elevated, what is this?
In bone
Reye’s Syndrome MOA?
aspirin metabolites=>decrease β-oxidation* by reversible inhibition of mitochondrial enzymes
When is only time to give aspirin to a child?
Kawasaki’s disease
Is Hepatic steatosis reversible?
Yes
Where will you see Mallory Bodies?
Alcoholic hepatitis
What are Mallory Bodies?
intracytoplasmic eosinophilic inclusions of damaged keratin filaments OR damaged IF
Alcoholic cirrhosis is reversible?
No
Alcoholic cirrhosis has what kind of appearance?
Hobnail
Esp. what site is affected by Alcoholic cirrhosis
Zone 3
Alcoholic cirrhosis without drinking alcohol
Non-alcoholic fatty liver disease
Non-alcoholic fatty liver disease MOA? Associated with?
insulin resistance=> fatty infiltration of hepatocytes=>cellular “ballooning” and eventual necrosis Obesity
With Hepatic Encepathopathy, dietary protein, GI bleed, constipation, infection would increase production or decrease removal of NH3?
NH3 production
With Hepatic Encepathopathy (due to renal failure, diuretics, bypassed hepatic blood flow post-TIPS) would increase production or decrease removal of NH3?
NH3 removal
Tx for Hepatic Encepathopathy?
Lactulose
jaundice, tender hepatomegaly, ascites, polycythemia, anorexia?
HCC
With HCC what specific carcinogen should you think of?
aflatoxin from Aspergillus
How does HCC spread?
Hematogenously